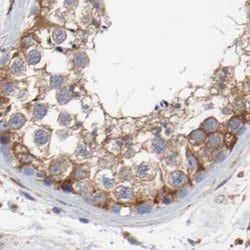
Invitrogen CD2AP Polyclonal Antibody 100 &mu;L; Unconjugated:Antikroppar

missing translation for 'onlineSavingsMsg'
Läs mer
Läs mer
Invitrogen™ CD2AP Polyclonal Antibody


Rabbit Polyclonal Antibody
Brand: Invitrogen™ PA551879
Denna artikel kan inte returneras.
Se returpolicy
Beskrivning
Immunogen sequence: WSGTLNNKLG LFPSNFVKEL EVTDDGETHE AQDDSETVLA GPTSPIPSLG NVSETASGSV TQPKKIRGIG FGDIFKEGSV KLRTRTSSSE TEEKKPEKPL ILQSLGPKTQ SVEITKTDTE GKIKAKE Highest antigen sequence identity to the following orthologs: Mouse - 82%, Rat - 83%.
This gene encodes a scaffolding molecule that regulates the actin cytoskeleton. The protein directly interacts with filamentous actin and a variety of cell membrane proteins through multiple actin binding sites, SH3 domains, and a proline-rich region containing binding sites for SH3 domains. The cytoplasmic protein localizes to membrane ruffles, lipid rafts, and the leading edges of cells. It is implicated in dynamic actin remodeling and membrane trafficking that occurs during receptor endocytosis and cytokinesis. Haploinsufficiency of this gene is implicated in susceptibility to glomerular disease.
Specifikationer
| CD2AP | |
| Polyclonal | |
| Unconjugated | |
| CD2AP | |
| adapter protein CMS; AL024079; C78928; Cas ligand with multiple SH3 domains; Cas ligand with multiple Src homology 3 (SH3) domains; CD2 associated protein; Cd2ap; CD2-associated protein; CMS; mesenchyme to epithelium transition protein, SH3 domains; mesenchyme-to-epithelium transition protein with SH3 domains 1; Mets1; METS-1; SH3 domain-containing adapter protein; SH3 domain-containing adaptor protein METS-1 | |
| Rabbit | |
| Antigen affinity chromatography | |
| RUO | |
| 12488, 23607, 316258 | |
| Store at 4°C short term. For long term storage, store at -20°C, avoiding freeze/thaw cycles. | |
| Liquid |
| Immunohistochemistry (Paraffin), Western Blot, Immunocytochemistry | |
| 0.10 mg/mL | |
| PBS with 40% glycerol and 0.02% sodium azide; pH 7.2 | |
| F1LRS8, Q9JLQ0, Q9Y5K6 | |
| CD2AP | |
| Recombinant protein corresponding to Human CD2AP. Recombinant protein control fragment (Product #RP-101069). | |
| 100 μL | |
| Primary | |
| Human, Mouse, Rat | |
| Antibody | |
| IgG |
Korrigering av produktinnehåll
Din input är viktig för oss. Fyll i det här formuläret för att ge feedback relaterad till innehållet på denna produkt.
Produkttitel
Hittar du en möjlighet till förbättring?Dela en innehållskorrigering